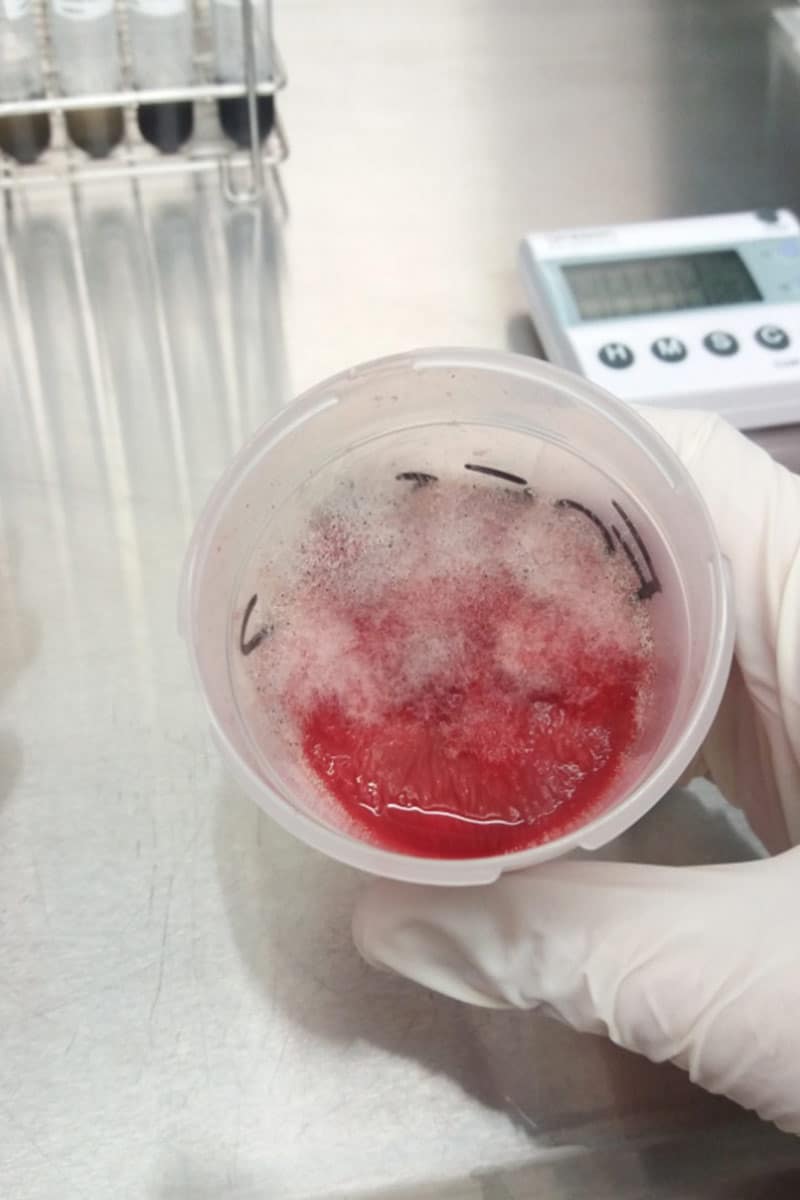

ANÁLISIS MICROBIOLÓGICO
Aún sin comprometer la seguridad alimentaria de nuestros productos, los microorganismos alterantes pueden hacer que éstos acaben siendo inaceptables para el consumidor. Controlar la presencia y los niveles de microorganismos alterantes en los alimentos previene la pérdida del valor comercial de nuestros productos a lo largo de su vida útil.
Las alteraciones de los alimentos dependen de sus propias características, de la microbiota que esté presente y de las condiciones ambientales que lo rodea. En función de todas estas condiciones se desarrollarán en nuestros productos diferentes microorganismos, algunos de los cuales pueden causar alteración o deterioro de los mismos. Tales microorganismos pueden estar presentes en la materia prima o tener acceso al alimento en alguna etapa del proceso de transformación. Es difícil evitar su presencia y una vez contaminado el alimento, si se mantiene por periodos largos bajo condiciones adecuadas para la multiplicación microbiana, será finalmente inaceptable para el consumidor.
El control analítico de microorganismos alterantes previene la pérdida de valor comercial de nuestros productos con anterioridad del fin de su vida útil, así como la posible pérdida de reputación de nuestra marca y de la confianza del consumidor.
Nuestras soluciones incluyen:
Algunos ensayos más específicos: bacterias acidolácticas, mohos y levaduras, levaduras osmófilas, levaduras resistentes al etanol, Alicyclobacillus spp. y Zygosaccharomyces rouxii.
| Responsable | AINIA |
| Domicilio | Calle Benjamín Franklin, 5 a 11, CP 46980 Paterna (Valencia) |
| Finalidad | Atender, registrar y contactarle para resolver la solicitud que nos realice mediante este formulario de contacto |
| Legitimación | Sus datos serán tratados solo con su consentimiento, al marcar la casilla mostrada en este formulario |
| Destinatarios | Sus datos no serán cedidos a terceros |
| Derechos | Tiene derecho a solicitarnos acceder a sus datos, corregirlos o eliminarlos, también puede solicitarnos limitar su tratamiento, oponerse a ello y a la portabilidad de sus datos, dirigiéndose a nuestra dirección postal o a privacy@ainia.es |
| Más info | Dispone de más información en nuestra Política de Privacidad |
| DPD | Si tiene dudas sobre como trataremos sus datos o quiere trasladar alguna sugerencia o queja, contacte al Delegado de protección de datos en info@businessadapter.es o en el Formulario de atención al interesado |
Consiento el uso de mis datos personales para que atiendan mi solicitud, según lo establecido en su Política de Privacidad.
Consiento el uso de mis datos para recibir información y comunicaciones comerciales de su entidad.
